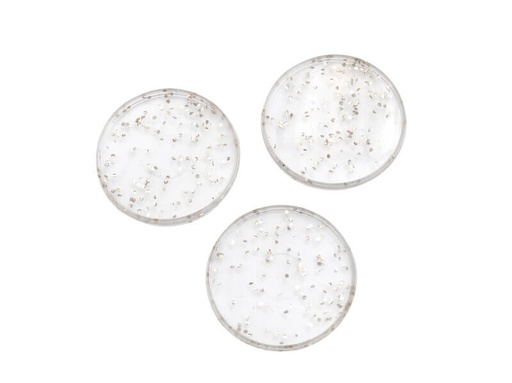
Discos Glitter Oro (mediano)

Discos Glitter Oro (mediano)
Este producto ya no está disponible.
Su fragmento dinámico se mostrará aquí...
Este mensaje se muestra porque no proporcionó un filtro y una plantilla para usar.